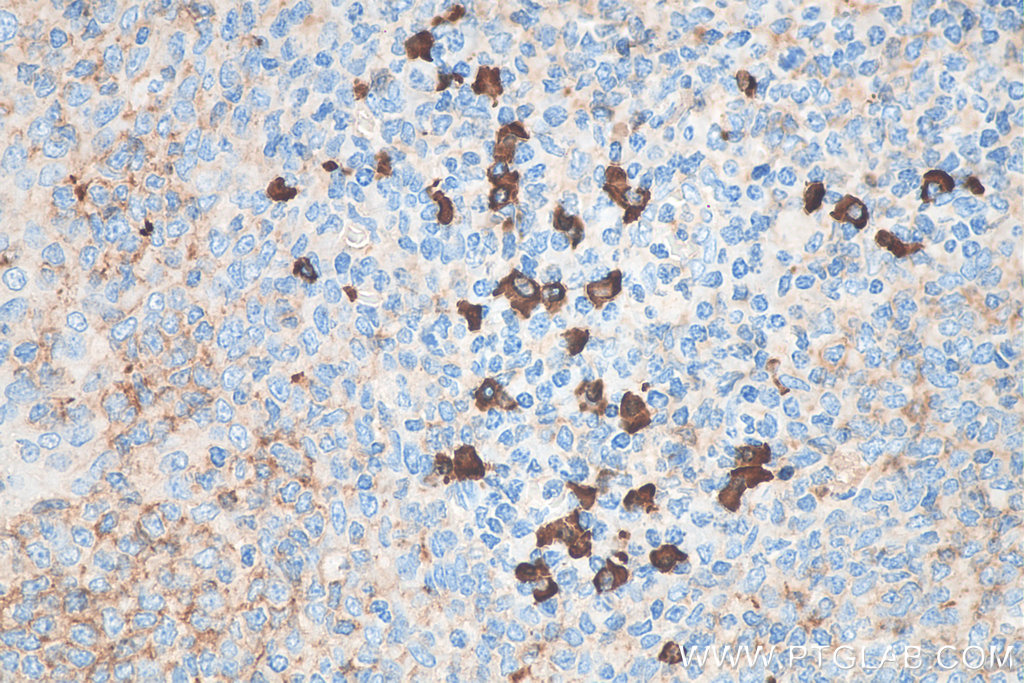
Biotin-conjugated Human IgA Heavy Chain Polyclonal antibody

Biotin-conjugated Human IgA Heavy Chain Polyclonal antibody
Biotin-conjugated Human IgA Heavy Chain Polyclonal antibody
Storage Temperature: Store at -20°C. Avoid exposure to light.
Species: human
Host: Rabbit
Application: IHC
GeneID: 3493
Size: 100
UL
Internal Reference:
BIOTIN-11449-100UL
Biotin-conjugated Human IgA Heavy Chain Polyclonal antibody Storage Temperature: Store at -20°C. Avoid exposure to light. Species: human Host: Rabbit Application: IHC GeneID: 3493 Size: 100 UL